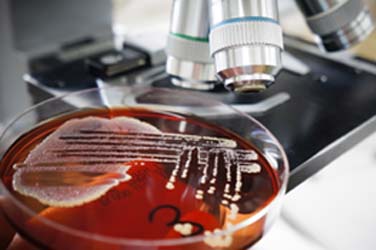

|
Wir tragen in weiterentwickelter und angepasster Form die sensorischen Strukturen der alten Meeresbewohner in uns. Unsere Gehörknöchelchen haben sich aus den Kiemenbögen der Reptilien entwickelt, die Ursprünge unserer Sinnesorgane, unseres Nervensystems, Gehirns und Immunsystems sind aus dem Leben im Meer entstanden. |
.jpg) |
| Das Leben im Meer kennt nicht die Begrenzung auf die traditionellen fünf Sinne, die man normalerweise dem Menschen zuspricht. Für das Leben im Meer werden mehr als fünf Sinne gebraucht; elektrische und magnetische Sinne sind nur zwei davon. Urwelttiere wie Quallen geben Hinweise auf die evolutionäre Entwicklung der Sinne. Geruch und Geschmack sind chemisch fundiert; Tast-und Geruchssinn sind eng mit dem Geschmackssinn verbunden, Bewegungssinn und Gleichgewichtssinn stehen in enger Verbindung mit Gehör und Tastsinn. | |
| Homöopathen arbeiten mit der Verbindung zwischen Sprache und Gefühl. Wir arbeiten mit dem ‚Skript‘ des Falles: die genauen Worte des Patienten beschreiben, wie er sich fühlt, wie wir es in der homöopathischen Prüfung wiederfinden. Jedes Mittel spricht in emotionalen und körperlichen Symptomen. Indem er seine Aufmerksamkeit auf die Sprache der Sinne richtet, kann sich der Homöopath der Essenz eines Falles mit größerer Klarheit nähern. | |
| Quallen, Korallen und Seeanemonen-Mittel (Nesseltier-Mittel): - Corallium rubrum (Rote Koralle) Anthozoa - Anthopleura xanthogrammica (Grüne Riesen-See-Anemone) Anthozoa - Stichodactyla haddoni (Haddon-See-Anemone) Anthozoa - Physalia pelagica (Portugiesisch: Krieger) Hydrozoa - Medusa oder Aurelia aurita (Ohren-Qualle) Scyphozoa - Chironex fleckeri (Würfel-Qualle) Cubozoa |
|
| Typische Gefühle der Nesseltiermittel - Brennen, Stechen, Nadeln, elektrischer Stromschlag, kribbeln, pochen, pulsieren - Fühlt sich an wie Wackelpeter, Schwäche, Zusammenbruch der Struktur, Taubheit, Leere - Jucken, kribbeln - Luxation, Zerstückelung, Desorientierung, Deaktivierung - Geschlagen - Schwellung, Vergrößerung, Dehnung - ausgepresst, gekniffen, komprimiert, Verengung, gezogen, zurückgezogen, unterdrückt Diese Gefühle können natürlich realen Schmerz mit einschließen, ebenso wie Wahnvorstellungen über die Beschaffenheit des Körpers. |
|
| Charakteristische Empfindungen der Nesseltiere - Hitze und Brennen, äußerliches Brennen und innere Kälte - Elektroschocks, pulsierende Schmerzen, Kribbeln, Taubheit - Pieken / Stechen - Luxation (Corallium rubrum) - Fehlende Substanz, Auflösung, Einstürzen, Schwäche mit Zittern, wie Wackelpeter - Gefühl von Schwimmen oder Fließen im Traum |
|
|
Gefühl von Entwurzelung |
|
| In der ersten Phase sind sie überempfindlich, hyperaktiv, eilig, stehen ständig unter Strom und haben die Tendenz, wie die sagenhafte Medusa „den Kopf zu verlieren“. In der nächsten Phase beschreibt der Patient Gefühle wie ‚nicht geerdet sein‘, fließen, nicht ganz in seinem Körper sein, desorientiert sein. In späteren Krankheitsstadien fühlen sie sich schwer, erschöpft, betäubt und emotional abgeschnitten. Es ist ein Gefühl von Unwirklichkeit und die Unfähigkeit, Kontakt mit der Umwelt aufzunehmen. | |
|
Dennoch haben sie auch innere Visionen und besitzen die Fähigkeit, Dinge jenseits unserer Realität zu sehen. Dies sind Mittel für Extreme: schnell und langsam, schwer und leicht, freudig oder apathisch, übersensitiv oder gefühllos, mit brennenden Symptomen. Nesseltiermittel brennen zuerst hell und brennen dann aus. |
|
|
- Emotional impulsiv: sie „verlieren den Kopf." überempfindlich, von Emotionen überwältigt, unkontrollierbare Reaktionen |
|
 |
- Hohe Empfindlichkeit gegenüber Schmerzen, |
| - Überreaktion, überempfindlich, schnell oder: dumpf, distanziert, abgehoben, langsam - Verlangen nach Musik, Tanz, Lachen, Freude oder: unfähig zu genießen. Abneigung gegen den Anblick der Freude anderer. Lachen irritiert ihn - Empfindlich gegen Grobheit oder: unhöflich, beleidigend und intolerant - Fehlende Anpassungsfähigkeit oder: „mit dem Strom schwimmen.“ - Verbundenheit, Erleuchtung, Leichtigkeit, schwebend, von Licht, Ruhe und Glückseligkeit erfüllt oder: getrennt, abgeschnitten, Dunkelheit, Schwere, Depressionen |
|
| Körperliche Symptome: Cardiovasculär. Immunsystem. Chronisches Erschöpfungssyndrom, postvirale Müdigkeit. Endokrines System (Zirbeldrüse, Hypophyse und Nebennieren). Neuromuskuläre Beschwerden. Arthritis. Urethritis. Haut: Urtikaria, Ödeme, Ekzeme, Geschwüre, Herpes. Magen-Darm: Durchfall, Vergiftung. Dehydration, Sonnenstich, Lichtempfindlichkeit. Husten, Keuchhusten, Sinusitis und Tonsillitis. | |
| ************************************************************************** | |
|
Dieser gekürzte Auszug aus SeaRemedies, Evolution of the Senses (Meeresmittel, die Entwicklung der Sinne, von Jo Evans veröffentlicht bei Emryss), zeigt die sensorischen Symptome von Heilmitteln aus dem Nesseltier Phylum auf: Korallen, Seeanemonen und Quallen. Das Buch ist beim Narayana-Verlag erhältlich: http://www.narayana-verlag.com/Sea-Remedies/Jo-Evans/b7346. |
|
| Das Buch Sea Remedies umfasst eine detaillierte Materia medica von 24 Mitteln aus einer Reihe von Stämmen sowie Kapitel, die sich der Erforschung der Entwicklung der Sinne widmen. | |
| Fotos: shutterstock.com | |
|
Kategorien: Allgemein |
|